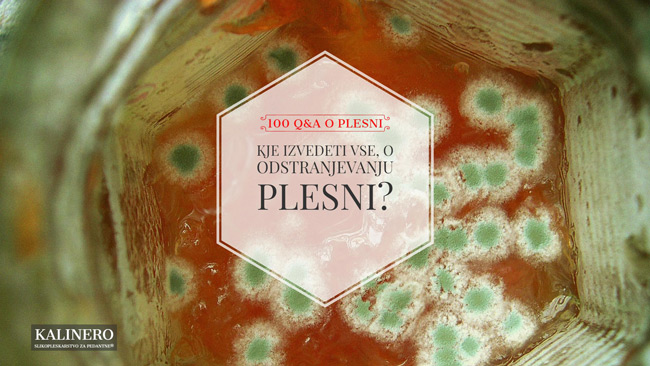
kje izvedeti vse o odstranjevanju plesni

Kje izvedeti vse, o odstranjevanju plesni?
Spremljajte odgovore na 100 najpogostejših vprašanj o plesni, ki so jih zastavili naši naročniki. Vsak petek rešim eno uganko in jo objavim na blogu ali enemu izmed socialnih omrežij.
Kaj pravijo naročniki na podajanje znanja:
"Toliko koristnih informacij o plesni na enem mestu nisem našla niti na internetu. Vsebina je razumljivo podana, le na začetku je precej strokovna in sem morala večkrat prebrat, da sem razumela.
Dobro je tudi, da je predstavljeno na praktičnih primerih in da so podane nekatere cene.
Skratka priporočam ga vsakomur, ki ima probleme s plesnijo. "
Karmen Vertačnik